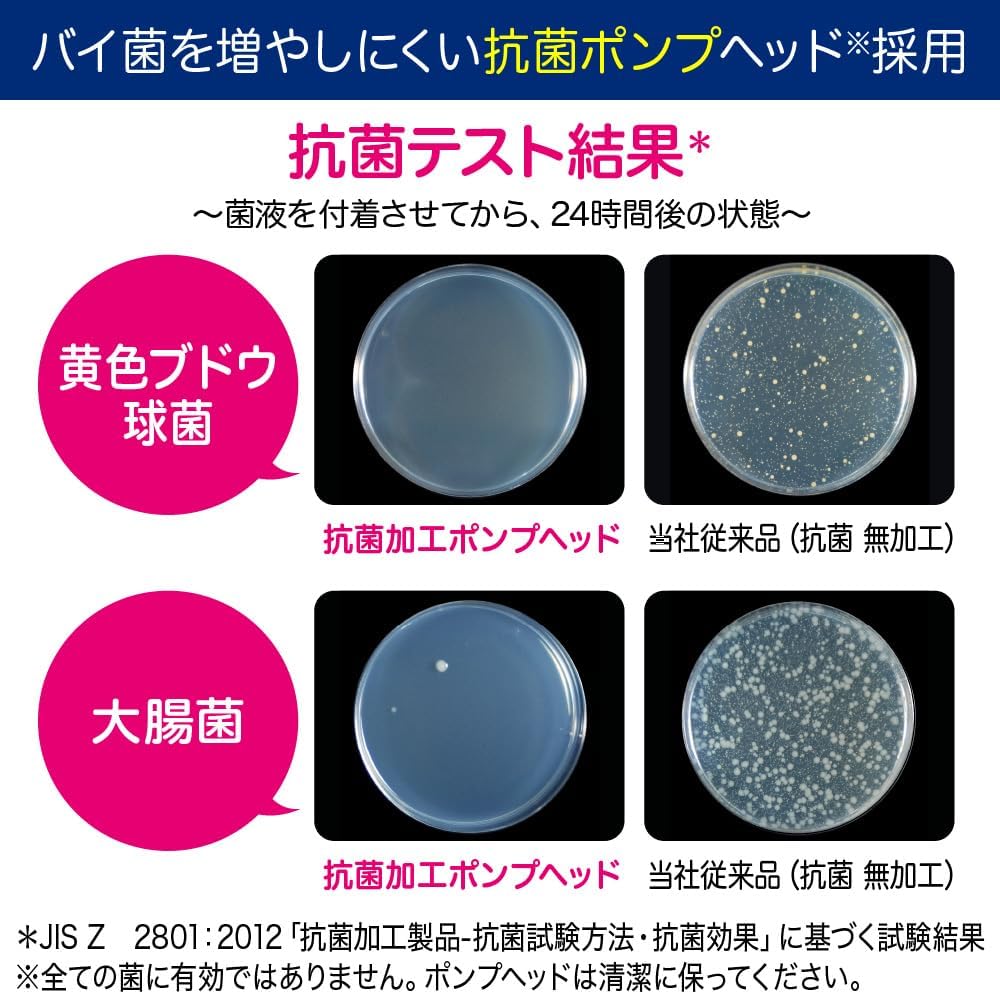
Biore Foaming Hand Soap Paw Stamp, 240ml (Exp 12/27)

Biore Foaming Hand Soap Paw Stamp, 240ml (Exp 09/28)
Biore Foaming Hand Soap Paw Stamp, 240ml (Exp 09/28)
Available in stock
Product Description
Product Description
Biore Foaming Hand Soap Paw Stamp is a fun and effective way to promote hand hygiene. Its paw-shaped design and long-lasting foam make handwashing enjoyable for kids and adults. The soap's antibacterial formula helps eliminate germs while being gentle on the skin. With a single push, you can dispense the perfect amount of foam for a thorough clean.
- Long-lasting foam that does not go flat during washing.
- One push makes it easy to wash every nook and cranny.
- The foam is long-lasting and foamy, yet can be rinsed off quickly.
- Contains antibacterial ingredients.
- Removes dirt, viruses, and bacteria.
- Mildly acidic, just like bare skin.
Note: This product is made for the Japanese Domestic Market (JDM) and is commonly recognized by consumers for its superior quality. Packaging may be in Japanese.
How to use
How to use
* Press the pump 3 to 4 times before first use.
Press down firmlyon the palm of your hand , release, and it 's done! * Do not press twice in a row. * If you use it with wet hands, it may not form a beautiful "paw".
If bubbles accumulate on the pump head, wash it by pouring water directly on it and drain it. (Water will not enter the bottle.) You can also remove the blue ring and plate on the top of the pump to wash it.
Ingredients
Isopropyl methylphenol*, water, polyoxyethylene lauryl ether ammonium sulfate (1E.O.) solution, PG, ethanol, PEG 6000, POE lauryl ether acetate, glyceryl ethylhexyl ether, acrylamide-acrylic acid-dimethyl diallyl ammonium chloride copolymer solution, trimethylammonio hydroxypropyl hydroxyethyl cellulose chloride, edetate, lactic acid, sodium hydroxide solution, benzoate, fragrance * Non-binding information